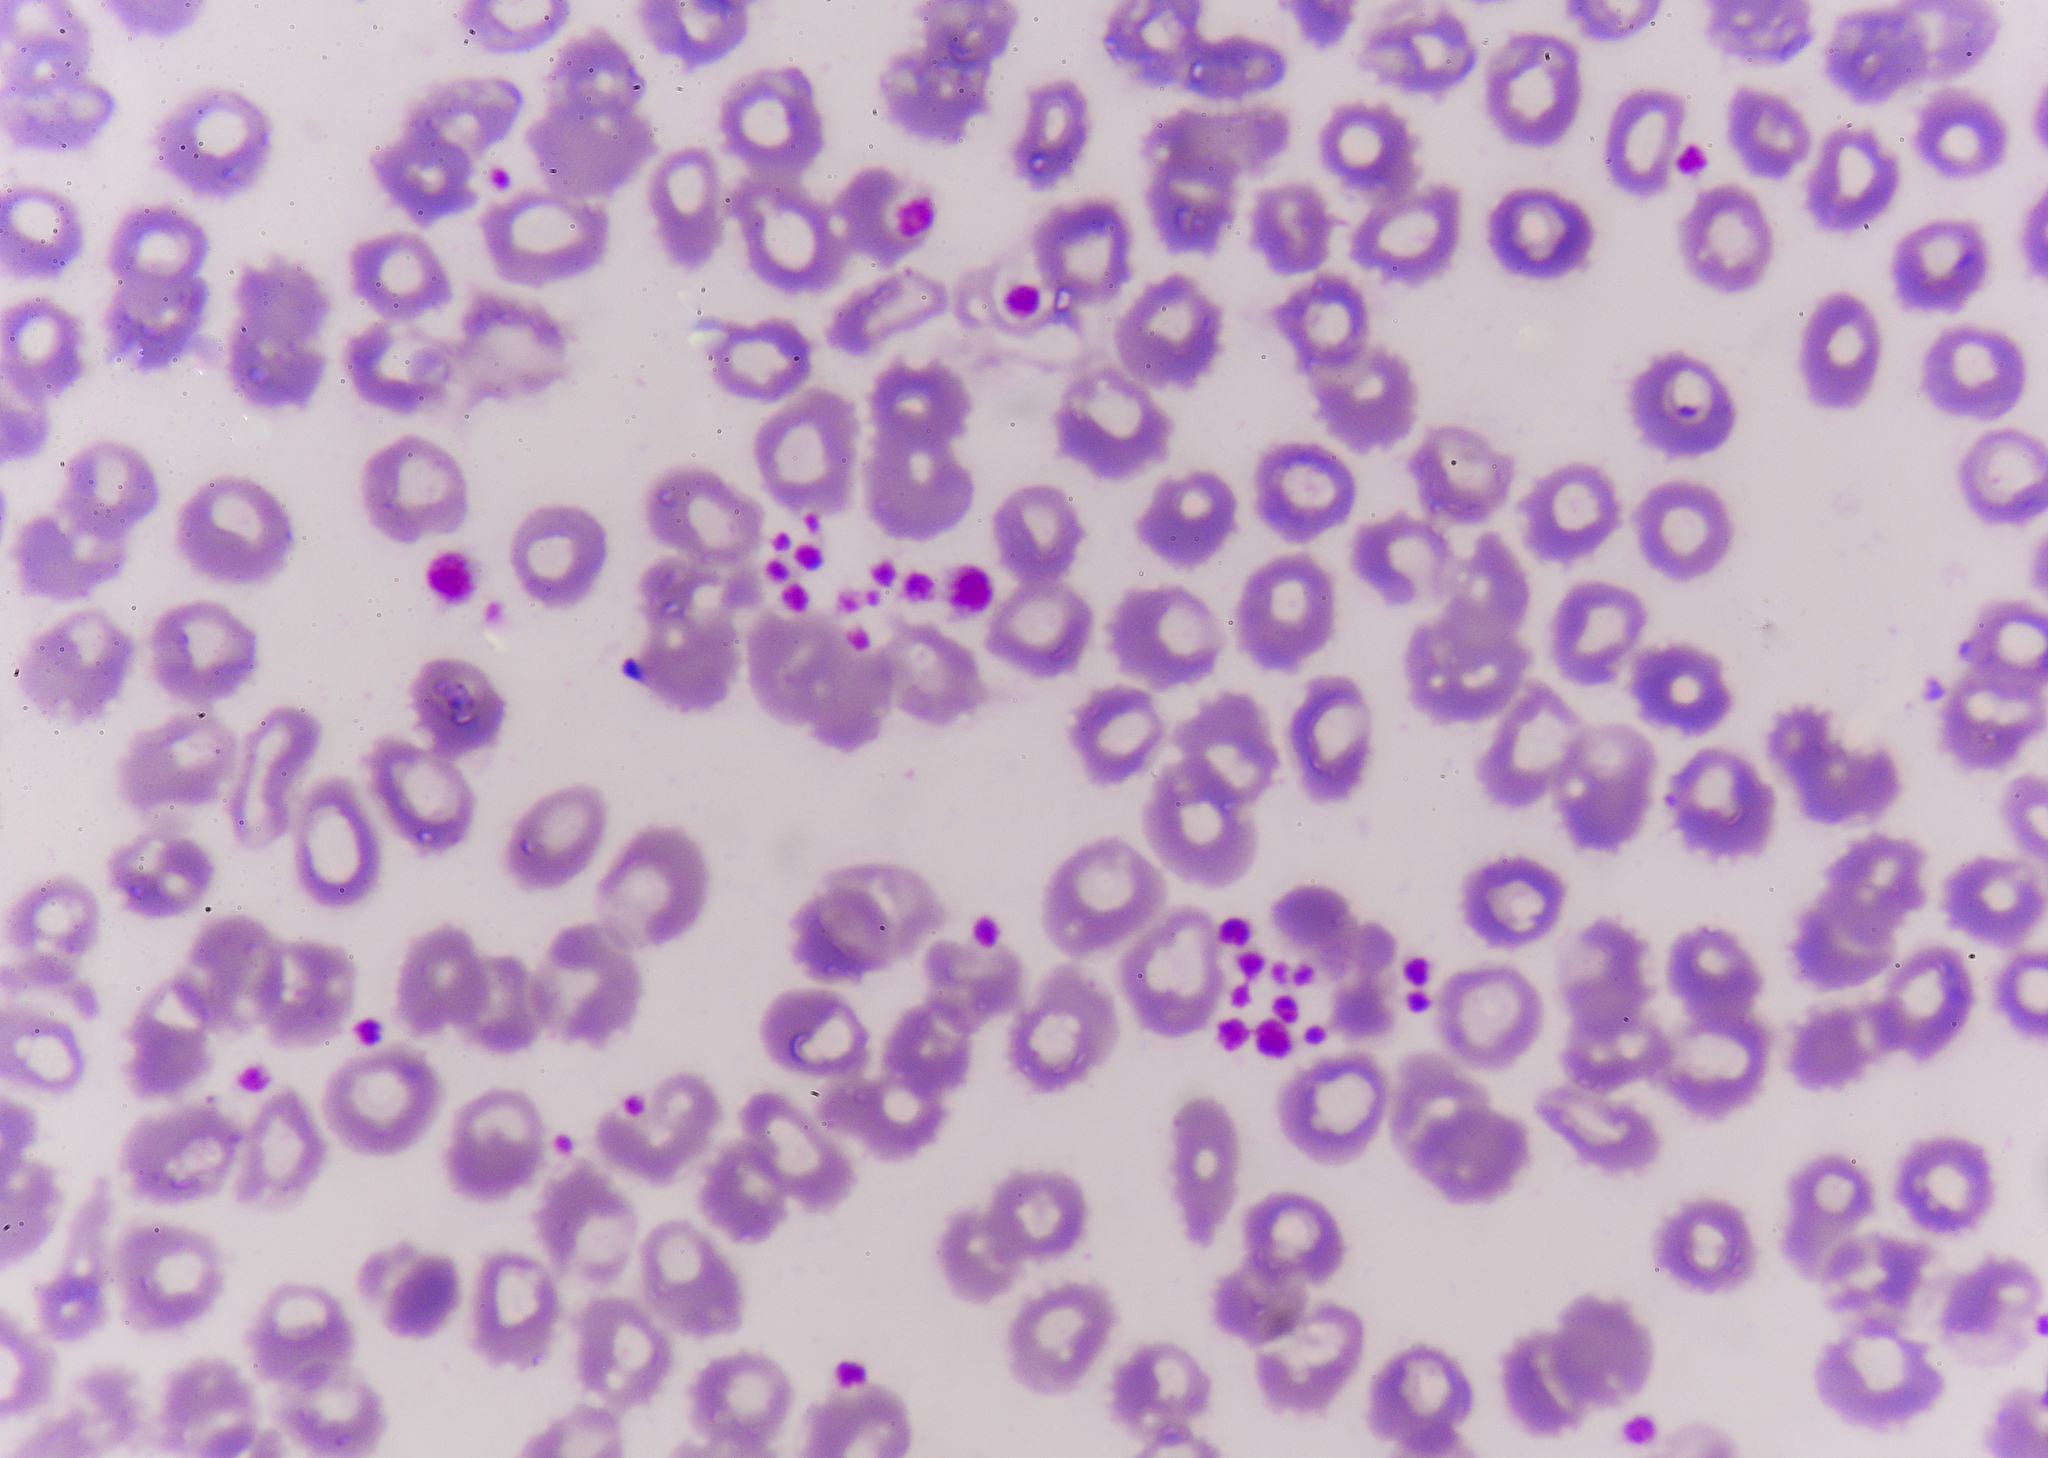
Urea Cargo Clumping: Causes, Inspection, and Recommendations

Urea Cargo Clumping: Causes, Inspection, and Recommendations
Our surveyor arrived at the shipside at around 1650hrs this afternoon and immediately inspected the bagged cargo. We observed clumping in the cargo, where the caked cargo could be easily crushed by hand and no obvious water was found.
In the case of urea, when the water vapor pressure in the surrounding air exceeds the saturation vapor pressure of the solution at that temperature, water in the air is absorbed onto the surface of the solid urea, increasing the water content. Over time, the urea can completely deliquesce. Conversely, if the water vapor pressure in the air is lower than the vapor pressure of water on the surface of the urea, the water will evaporate and transform back into a solid.
During the storage and stacking process of urea, the granules come into close contact with each other. With changes in temperature and humidity, the urea granules undergo a process of moisture absorption and evaporation on their surface, resulting in recrystallization and the formation of a liquid film. The newly crystallized urea particles stick together with other crystals, causing clumping.
Therefore, the occurrence of clumping usually indicates that the cargo may have been stored for a long time or exposed to a humid environment.
Due to the current storage and transportation conditions of urea, it is almost inevitable to have pseudo-clumping (normal water content) during bulk cargo transportation. Based on our experience, a common method to determine whether the cargo is pseudo-clumped is to check if the clumped cargo can be easily crushed. If the cargo can be easily crushed, we consider the condition of the cargo to be within an acceptable range. Otherwise, the moisture content of the cargo may be higher. In such cases, we recommend removing the affected cargo to prevent it from affecting other cargo.
Furthermore, to protect the interests of the shipowner, we suggest adding appropriate annotations on the mate's receipt. We will provide specific annotation recommendations after further inspecting the cargo. We hope this information is helpful. If you have any questions, please feel free to contact me.
原文地址: http://www.cveoy.top/t/topic/foE7 著作权归作者所有。请勿转载和采集!